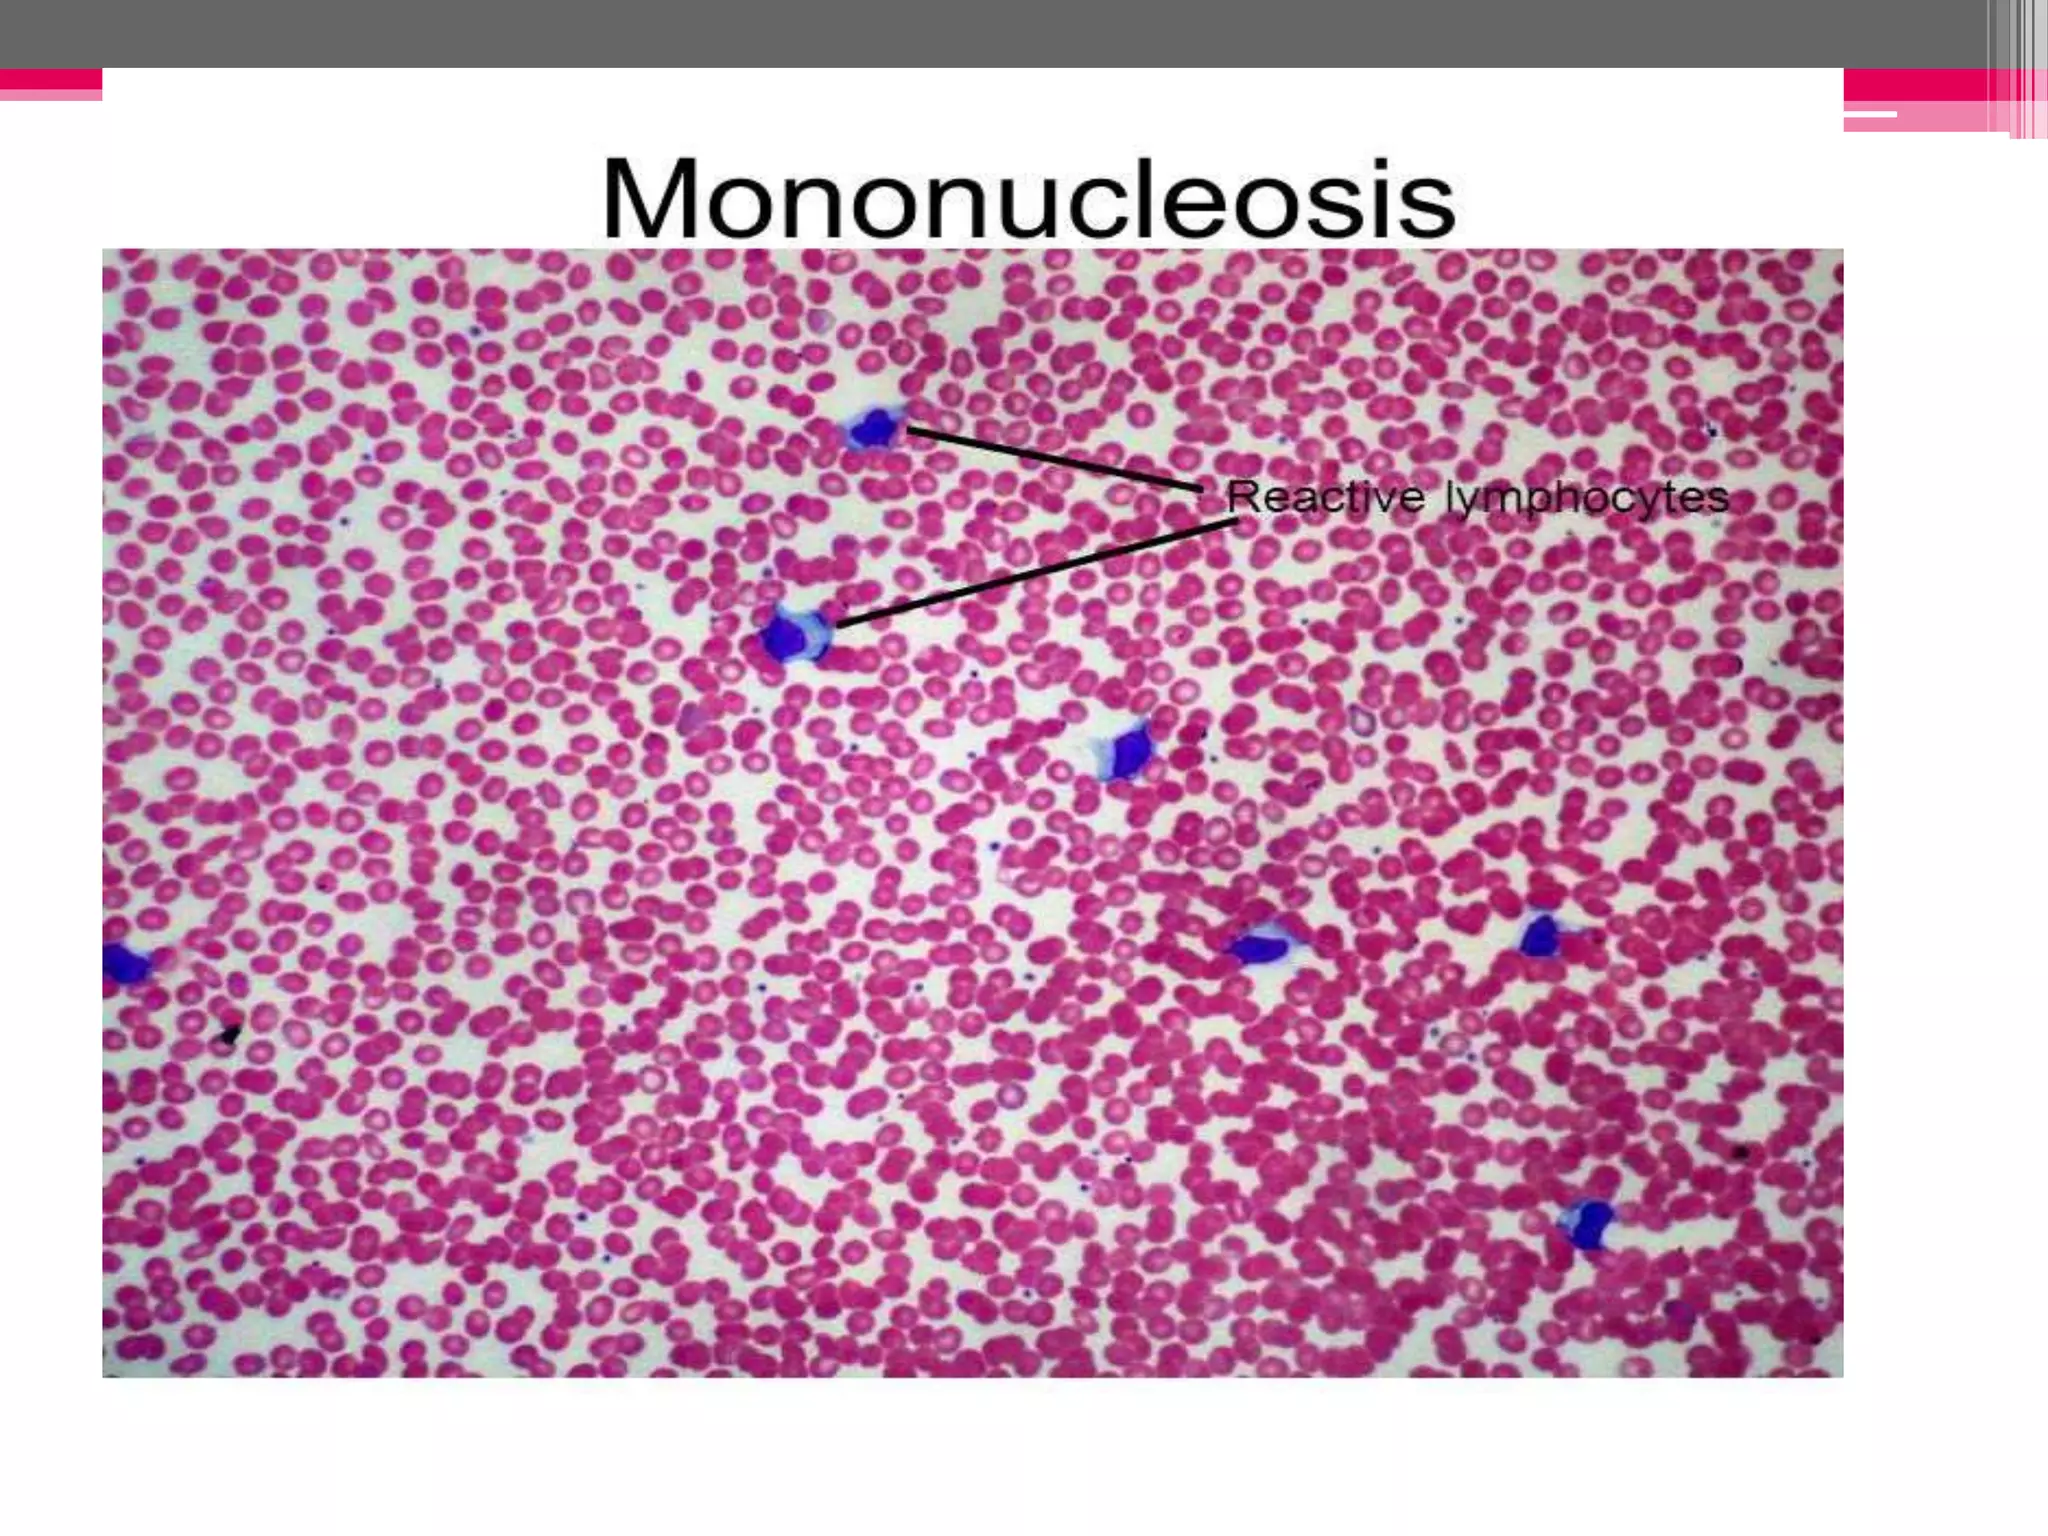

Embed presentation
Downloaded 14 times


























Epstein Barr virus and Varicella Zoster virus are herpes viruses. EBV causes infectious mononucleosis and is associated with various cancers like Burkitt's lymphoma. It remains latent in B cells after initial infection. Varicella Zoster virus causes chickenpox during primary infection and shingles during reactivation from latency in dorsal root ganglia. Both viruses are enveloped with double stranded DNA and spread via contact with infected secretions. Their infections present with fever and rashes and are diagnosed via blood tests or virus detection.